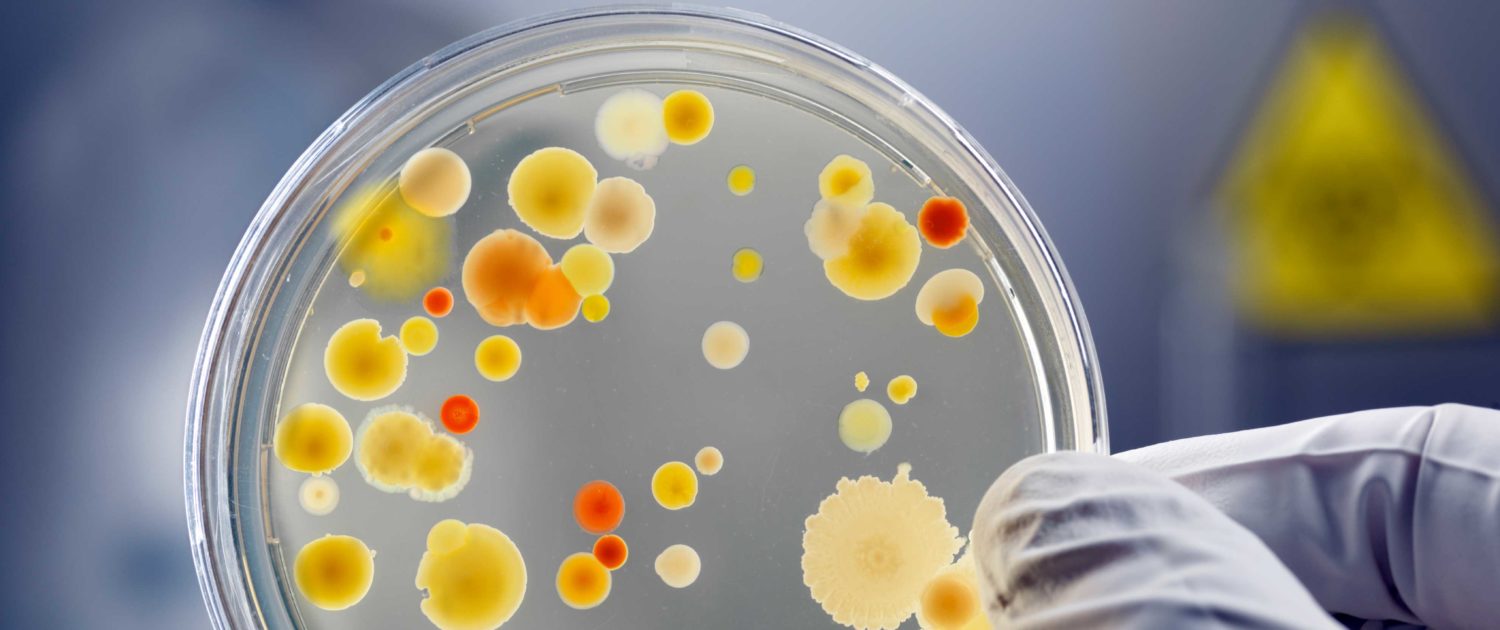

Professional guidelines for ham and goat and sheep milking
Nýjar faggreinaleiðbeiningar um hangikjöt annars vegar og geita- og sauðamjaltir hins vegar eru nú aðgengilegar hér vefsíðu Matís. Um er
Professional guidelines for ham and goat and sheep milking More »